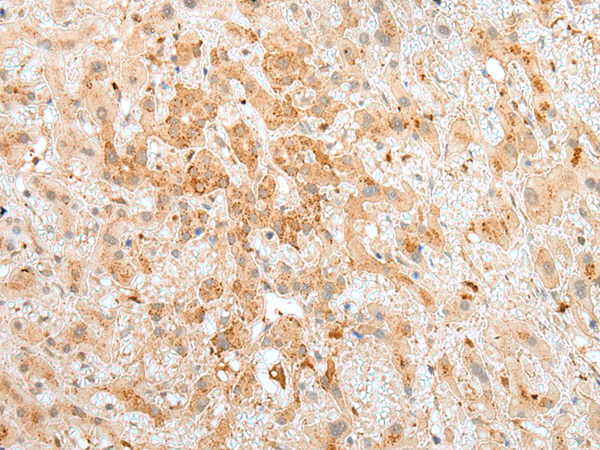
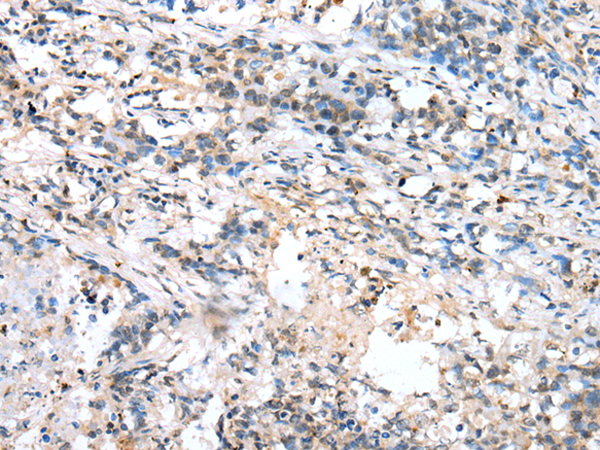
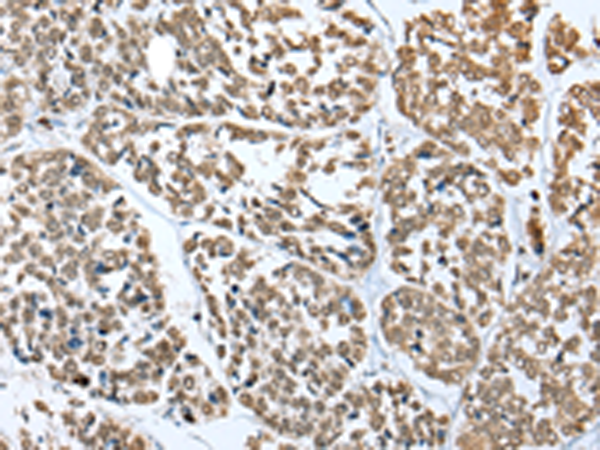
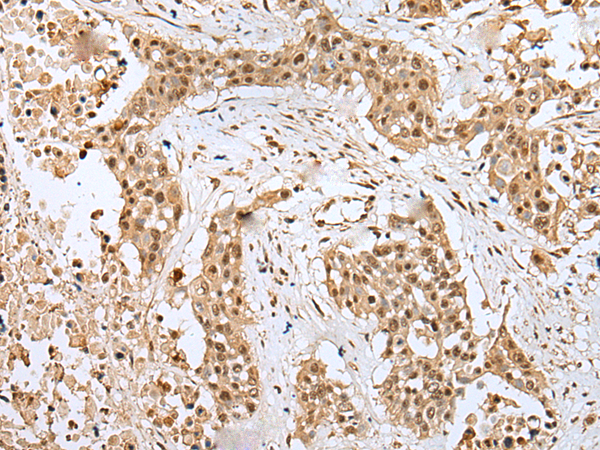
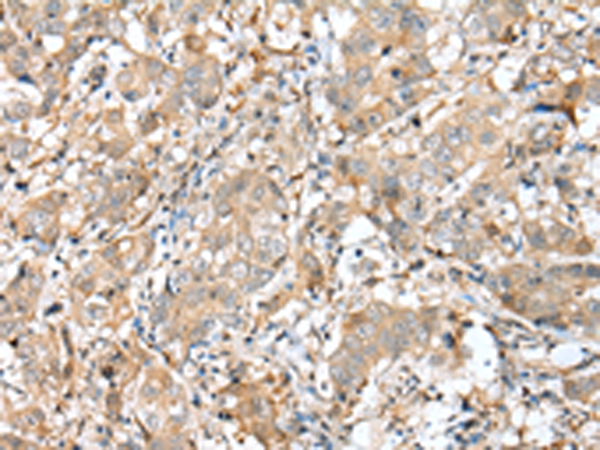

-
分类: 科研抗体货号: P09142别名: RIFK应用: WB,IHC反应种属: Human, Mouse
-
分类: 科研抗体货号: P09119别名: APAH1应用: WB,IHC反应种属: Human, Mouse, Rat
-
分类: 科研抗体货号: P09134别名: MSAP; TMEM4; ZSIG9; HP10390应用: WB,IHC反应种属: Human, Mouse
-
分类: 科研抗体货号: P09141别名: TNC; TN-C; TNNC; CMD1Z; CMH13应用: WB,IHC反应种属: Human, Mouse
-
分类: 科研抗体货号: P09150别名: GXII; ROSSY; PLA2G12应用: IHC反应种属: Human, Mouse
-
分类: 科研抗体货号: P09132别名: CORS; CORCS; CTRP3; CORS26; C1ATNF3; CORS-26应用: WB,IHC反应种属: Human, Mouse
-
分类: 科研抗体货号: P09140别名: CIA2A; FAM96A应用: WB反应种属: Human, Mouse
-
分类: 科研抗体货号: P09149别名: RHEBL1c应用: IHC反应种属: Human, Mouse, Rat
-
分类: 科研抗体货号: P09130别名: TMG3; PRGP3应用: WB反应种属: Human, Mouse
-
分类: 科研抗体货号: P09137别名: FKBP36应用: WB,IHC反应种属: Human, Mouse, Rat

鄂公网安备42018502007531号
鄂公网安备42018502007531号

